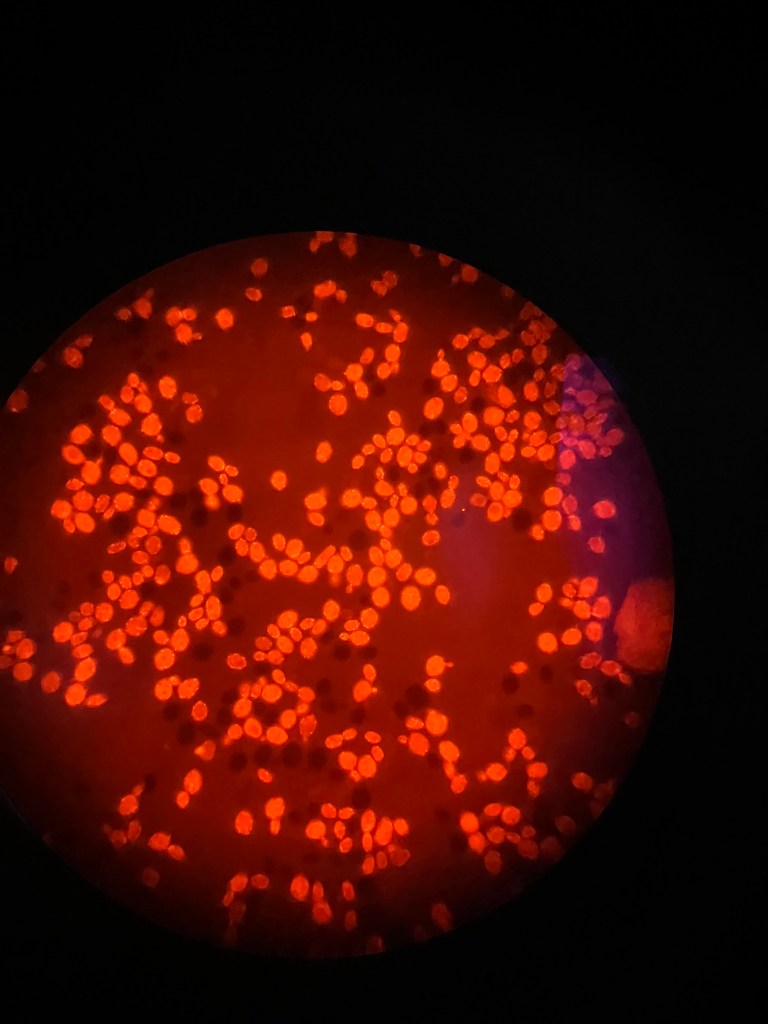

Categories

Research
Description
Research is the art of exploration. Exploring the unknown is my ultimate passion, and I aim to dedicate my life to exploring the limits of biology and engineering. For now, this category of posts includes the elementary practical lab work I’ve done. I am eager to fill this category with my own personal novel research once I have the academic and financial resources to pursue the art on my own accord.

Biology
Description
Biology is the study of nature’s machines. Modern understanding of biology exists thanks to the work of a great deal of people, from formal academic biologists, to physicists, chemists, and Austrian priests. This category of projects is any and all things related to personal biology projects.